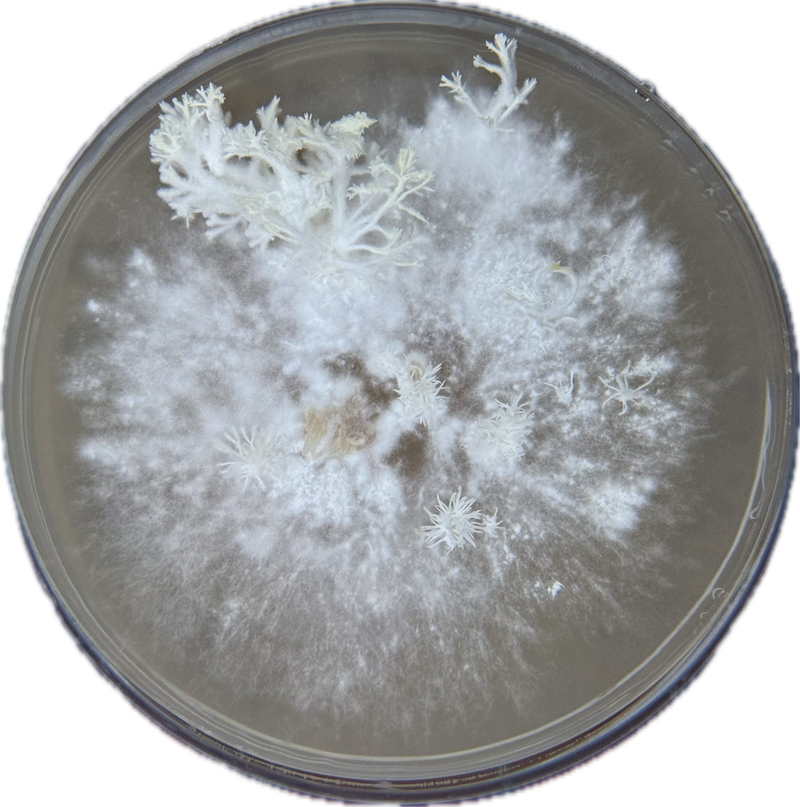

Verið velkomin!
North Tropics var stofnað árið 2021 með eina hugsjón að leiðarljósi – að rækta og framleiða náttúrulega heilsuvöru sem raunverulega virkar.
Síðan þá hefur teymið unnið hörðum höndum að þróun vörunnar, með það að markmiði að sameina hreinleika íslenskrar náttúru við vísindi og virkni sem styður við líkama og huga.
Fyrsta varan okkar, Lion’s Mane sveppurinn, er nú tilbúin eftir þrjú ár af rannsóknum, ræktunartilraunum og samstarfi við íslenska bændur og brautryðjendur. Við notum aðeins sveppaldin – virkastu hluta sveppsins – og íslenskt lindarvatn.
Við vinnum náið með íslenskum framleiðendum að sjálfbærri hringrás – þar sem hráefni eru nýtt til fulls og ekkert fer til spillis.
North Tropics er reist á traustum gildum: hreinskilni, virkni og virðingu fyrir náttúrunni.
Við seljum ekki bara vöru – við bjóðum upp á leið til að lifa lífinu í betra jafnvægi.
Skoða vörur